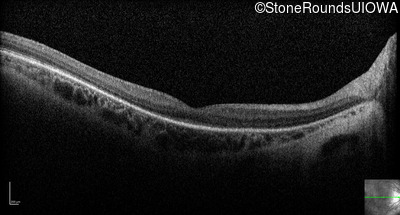
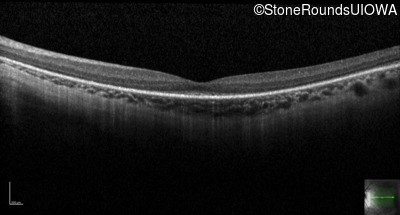
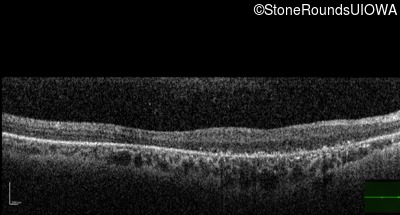

Case
SR1058
Student Mode
Bardet Biedl Syndrome (IB2)
Male
Male
Hidden
SR1058
Student Mode
Bardet Biedl Syndrome (IB2)
Male
Male
Diagnosis & molecular findings
| Disease | Gene | Allele 1 variant(s) | Allele 2 variant(s) | Inheritance mode |
|---|---|---|---|---|
| Bardet Biedl Syndrome | MKKS | Gln282Stop CAG>TAG | Trp478Arg TGG>CGG | AR |
Disease:
Gene:
Allele 1:
Gln282Stop CAG>TAG
Allele 2:
Trp478Arg TGG>CGG
Inheritance:
AR